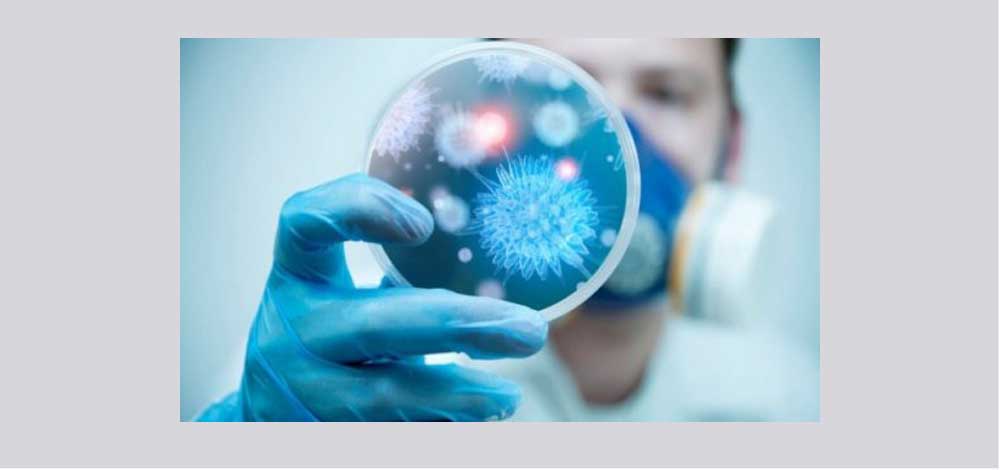

صحة أبوظبي: وفاة شخص بفيروس كورونا وإصابة آخر
أعلنت هيئة الصحة أبوظبي - الهيئة التنظيمية لقطاع الرعاية الصحية في إمارة أبوظبي، اليوم، عن وفاة شخص غير مواطن يبلغ من العمر 65 عاما بسبب إصابته بـ "فيروس كورونا" المسبب لمتلازمة الشرق الأوسط التنفسية في أبوظبي.
كما أعلنت أيضا عن حالة أخرى تم تأكيد إصابتها بالفيروس ولكنها مستقرة وتحت الملاحظة ..ومن المنتظر أن تتخلص من الفيروس وتغادر المستشفى قريبا.
وأكدت الهيئة أنها بالتنسيق مع وزارة الصحة والهيئات الصحية والجهات المعنية في الدولة اتخذت الإجراءات الاحترازية الضرورية اللازمة للحالتين وفقا للتوصيات العلمية والشروط والمعايير المعتمدة من منظمة الصحة العالمية مثل التقصي النشط والعزل.
بدورها قالت وزارة الصحة إن مراكز التقصي الوبائي في الدولة تعمل على مدار الساعة للإبلاغ المبكر عن أي حالات للفيروس ..مؤكدة أن النظام الصحي بالدولة فعال وأن الوزارة تتابع الوضع عن كثب بما يضمن صحة وسلامة الجميع.
![]() تابعوا آخر أخبارنا المحلية والرياضية وآخر المستجدات السياسية والإقتصادية عبر Google news
تابعوا آخر أخبارنا المحلية والرياضية وآخر المستجدات السياسية والإقتصادية عبر Google news



